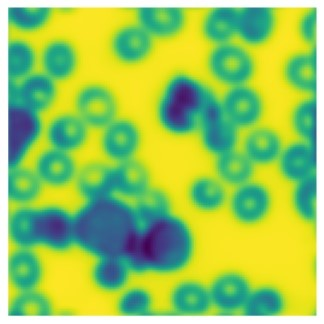

Optical imaging quality can be severely degraded by system and sample induced aberrations. Existing adaptive optics systems typically rely on iterative search algorithm to correct for aberrations and improve images. This study demonstrates the application of convolutional neural networks to characterise the optical aberration by directly predicting the Zernike coefficients from two to three phase-diverse optical images. We evaluated our network on 600,000 simulated Point Spread Function (PSF) datasets randomly generated within the range of -1 to 1 radians using the first 25 Zernike coefficients. The results show that using only three phase-diverse images captured above, below and at the focal plane with an amplitude of 1 achieves a low RMSE of 0.10 radians on the simulated PSF dataset. Furthermore, this approach directly predicts Zernike modes simulated extended 2D samples, while maintaining a comparable RMSE of 0.15 radians. We demonstrate that this approach is effective using only a single prediction step, or can be iterated a small number of times. This simple and straightforward technique provides rapid and accurate method for predicting the aberration correction using three or less phase-diverse images, paving the way for evaluation on real-world dataset.
翻译:暂无翻译